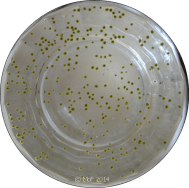
Cyanobakterier

Jag har fått en ny kund, är datorberoende och har blivit kulturell. Mia gillar vedkorgen.
Ny kund
I torsdags fick Din Konsult en ny kund som behövde hjälp med att skapa en webbsajt. Sånt befattar jag mig inte med på grund av bristande kunskaper, så mitt råd var att välja en av fyra leverantörer som tillhandahöll allt som behövdes.
Ett av förslagen föll i god jord. För ca 100 € per år får kunden tillgång till webbserver, eget domännamn och färdiga sidmallar. Det enda han själv behöver göra är att välja layout, färgsättning och skapa innehåll förstås.
Det tyckte kunden var en bra lösning, så vi registrerade sajtens namn och övriga uppgifter som krävdes. Lätt som en plätt. 🙂
Datorberoende
Härom dagen kom jag på att jag har använt datorer som arbetsverktyg sen 1975. Det betyder 44 år, ungefär ett halvt liv. Inte att undra på att jag är datorberoende!
I början på 70-talet var verktygen ord‑ och textbehandlingsutrustningar. De första hade enbart intern‑ och externminnen för att senare följas av modeller med bildskärm och mus.
Jag minns att jag inte fattade vad jag skulle med musen till i början. Det fanns ju funktionstangenter för markörförflyttningen? Bildskärmen underlättade förstås hanteringen även om jag visste exakt hur texten såg ut i internminnet.
Då PCn kom till Sverige 1981 hade jag redan hunnit arbeta en del med s k mikrodatorer, så övergången till PC var inte så stor. Dock var programvaran inte mycket att hurra för i början, men utvecklingen gick fort som bekant.
Redan då förutspådde jag att PCn skulle bli en ”all-round-maskin”, dvs man skulle kunna använda den till ”allt”. Jag fick rätt. Numera finns det få arbetsuppgifter som inte kan lösas eller underlättas med datorns hjälp.
Och själv är jag givetvis en hängiven användare. Nästan allt jag behöver veta eller göra finns i datorn.
Blivit kulturell
Jag har blivit kulturell på senare tid. Tidigare har jag alltid påstått att jag är kulturanalfabet, men man kan ju ändra sig vetja. Fast i vissa kretsar skulle mitt nymornade intresse knappast godkännas som ”finkultur” misstänker jag.
Teaterbesöket i Fallåker i början på februari följs härnäst av Mark Levengood den 21.3, pianokonsert den 30.3, teater den 4.4 och Babben Larsson den 11.4. Ganska späckat framöver med andra ord.
På vår ö är kulturutbudet både digert och mångsidigt som man kan se i öns händelsekalender. Utöver evenemangen som annonseras där anordnas också många andra, så det torde finnas något för alla och envar oavsett smak och intresse.
Mia gillar vedkorgen
Med tanke på Mias förtjusning i vedkorgen borde vi kanske skaffa en egen korg till henne? Så snart vedlagret har minskat så mycket att hon får plats lägger hon sig i den. En tom korg är förstås ändå bättre. 🙂